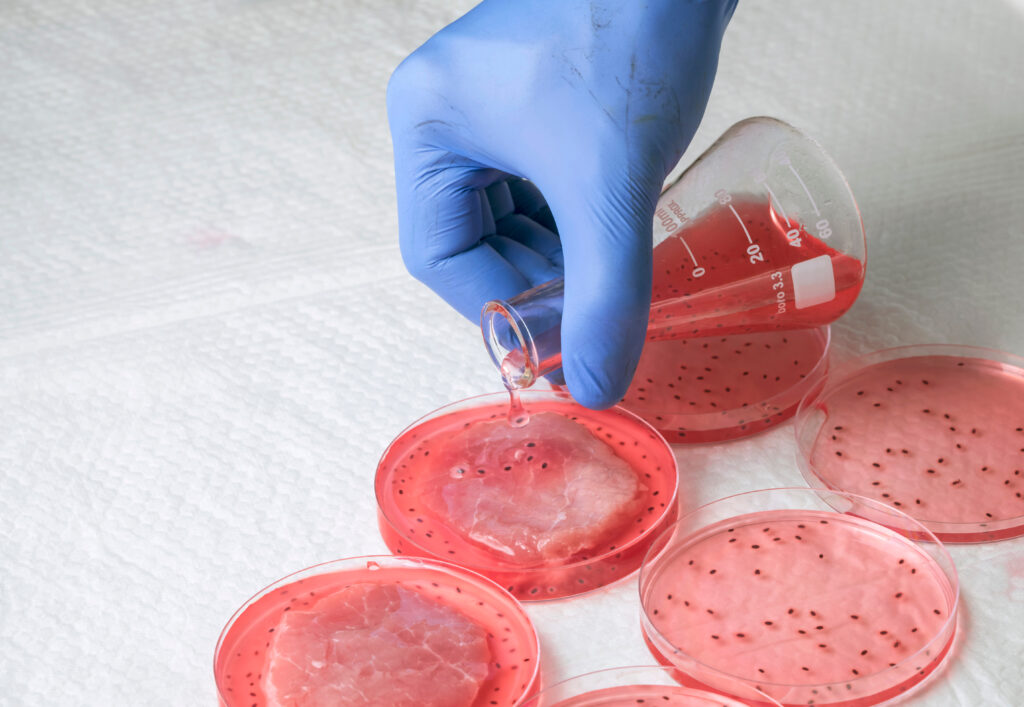

Kultivované maso je budoucností stravování: Je libo hamburger z laboratoře?

Počet obyvatel Země nedávno překročil hranici osmi miliard. Vědci si lámou hlavu nad tím, jak dlouho nás planeta zvládne uživit a snaží se přijít s řešením. Kultivace masa by mohla být jedním z nich. Ujmou se ve společnosti hamburgery a steaky vypěstované v laboratořích, nebo nad nimi lidstvo ohrne nos?
Není žádným tajemstvím, že živočišný průmysl představuje velkou zátěž pro životní prostředí. Umělé maso má potenciál s problémem zatočit. Vyrábí se kultivací zvířecích buněk bez nutnosti porážky, než se ale objeví v menu českých restaurací, budete si muset ještě počkat.

Fenomén dnešní doby kratom: Proč si na něj dát pozor a kdy jste zralí na odvykačku
Výroba umělého masa
Trh s vegetariánskými a veganskými výrobky stálé vzkvétá, uměle vypěstované maso bylo však zatím schváleno k prodeji pouze v Singapuru. Nicméně trendy hovoří jasně, už více než 100 podniků na celém světě se tímto odvětvím intenzivně zabývá. Řadí se mezi ně i český start-up Bene Meat Technologies.
Kultivované maso se dá vyrábět dvěma způsoby: Biopsií z živého zvířete, nebo odběrem z těch čerstvě poražených. „Aktuálně odebíráme vzorky tkání na jatkách z čerstvě poražených zvířat. Ono to není jen tak štípnout zvíře, na to je potřeba poměrně hodně papírů i povolení a na to nemáme čas,“ vysvětluje Roman Kříž, vedoucí projektu Bene Meat Technologies. Do budoucna by chtěl ale vzorky získávat druhou cestou.

Kultivované maso mohou jíst i zvířata
Buňky z jednoho zvířete však není možné odebírat příliš často. „Až budeme vzorky získávat pomocí biopsie, budeme to moci dělat, tuším, dvakrát nebo snad čtyřikrát ročně. Nevím to přesně, protože to aktuálně ještě neřešíme. Ale časem se k tomu dostaneme, počítáme s tím, protože etický rozměr je pro nás dost důležitý,“ říká Roman Kříž, který se momentálně věnuje také technologii výroby surovin pro krmivo určené domácím mazlíčkům. Věděli jste, že právě produkce krmiv pro domácí mazlíčky je při své velikosti zodpovědná za 25 % uhlíkové stopy v oblasti chovu zvířat? I zde by tedy kultivace masa mohla najít široké uplatnění.
Benefity alternativních bílkovin
Možnost přejít na bílkoviny, jejichž výroba je ekologická a navíc nezahrnuje utrpení zvířat, představuje revoluci v potravinářském průmyslu i zemědělství. „Z hlediska welfare zvířat, ochrany životního prostředí, biodiverzity a klimatu jsou výhody kultivovaného masa jednoznačné. Není třeba rozmnožovat, vykrmovat a zabíjet zvířata. To se v současnosti děje většinou velmi intenzivním způsobem v průmyslových velkochovech, které jsou závislé na obrovském množství krmiv, často dovážených z dalekých zemí a pěstovaných běžně v monokulturách, které se neobejdou bez notných dávek umělých hnojiv a pesticidů,“ tvrdí Romana Šonková z organizace Compassion in World Farming (CIWF).
Klasické versus umělé maso
Přestože se i na českém trhu kultivované maso uplatnit může, část společnosti s ním souznít nebude. „Někteří vnímají kultivované maso, na rozdíl od masa ze zabitého zvířete, jako něco nepřirozeného. Je to sice pochopitelné, ale lidé si mnohdy neuvědomují, že naprostá většina zvířat, která nám v současnosti poskytují maso, žije v naprosto nepřirozeném prostředí a je často krmena nepřirozenou stravou. Věřím, že tady by pomohla rozumná osvěta,“ říká Romana Šonková.
Maso pro vegany?
Kultivované maso je určeno hlavně pro ty, kteří se nechtějí vzdát konzumace masa, zároveň se ale touží stravovat udržitelněji. Oslovit by však mohlo i vegany či vegetariány. „Bude záležet na tom, z jakých důvodů se ten který člověk vegetariánem nebo veganem stal. Pokud se rozhodl z etických důvodů, to znamená, že mu vadilo špatné zacházení a zabíjení zvířat, nebo třeba z důvodu klimatické změny či dalších environmentálních důvodů, pak ho může kultivované maso zaujmout. Pokud někdo nejí maso ze zdravotních důvodů – a takových lidí také není málo, pak ho asi kultivované maso nezláká,“ zamýšlí se Romana Šonková.

Fotky i kondomy aneb Věci, které nejsou veganské a možná jste to nevěděli

Singapur povolil kuřecí nugety z laboratoře
Autorský článek
Zdroj fotografií: Shutterstock


